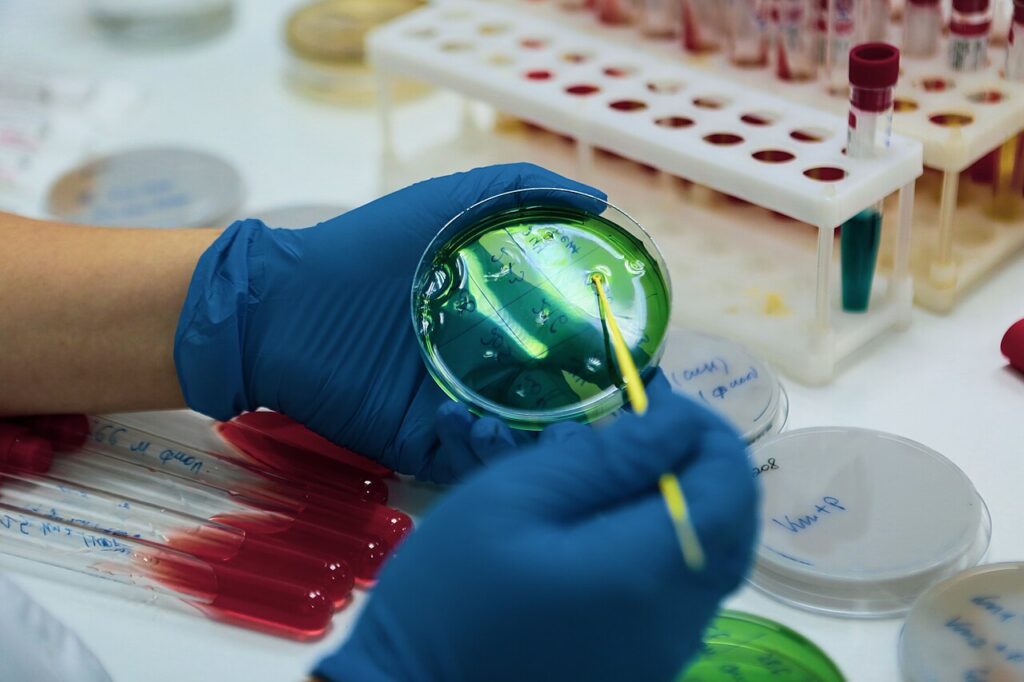

У сенци једне лондонске лабораторије почетком двадесетог века, погрбљен човек је стајао пред светом невидљивим голим оком, без оружја и видљиве силе, али са огромним стрпљењем, упорношћу и опажањем које само ретки поседују. Александар Флеминг је, нагнут над микроскопом у тишини проучавао бактерије, у просторији где ће један случајан догађај револуционарно да промени историју. Заувек.
Једног јутра, у редовима својих Петријевих посуда, приметио је мали неправилан круг на једној од њих. Бактерије на том месту нису преживеле. За некога ко не би обратио пажњу и разумео њено значење, то је могла да буде само незнатна разлика.
Али за Флеминга је то био историјски глас природе која је открила своју тајну. Она је тихо, а одлучно указала да постоје закони микроскопског света које човек може разумети, оружје које може спасити животе и судбине читавих генерација у будућности.
То није био само круг настао падом плесни на отворену колонију бактерија у Петефијевој шољи који их је убио. То је био знак да се свет мења, да се вековне невидљиве и непознате силе природе могу претворити у савезнике човека, ако уме да гледа, да разуме, и да верује у значај чак и случајних открића. Лабораторија је постала место борбе живота и смрти, где је један мали круг на стаклу посудице отворио врата која свет није ни слутио да постоје.
Пеницин – симбол нове ере
Флеминг је пажљиво проучавао тај круг, бележио сваки детаљ и дао му име пеницилин, по латинском називу плесни Penicillium notatum, која је у тој Петефијевој посуди оставила свој потпис човеку. Та супстанца није само уништавала бактерије као ни једна до тада – она је најављивала нову еру, у којој човечанство почиње да савладава болести које су вековима харале светом.
Пеницилин је показао своју снагу у борби против стрептококних и стафилококних инфекција, упала плућа, сифилиса, гонореје, тетануса и многих других болести које су раније узимале животе без икакве могућности да оболели преживе. Један круг на Петријевој посудици је постао симбол могућности да човек уђе у нову фазу контроле и разумевања природе, као и преживљавања до тада неизлечивог.
Тог тренутка откриће није било спектакуларно у класичном смислу, али је временом показивало своју огромну снагу: први пут је човек могао да се успешно супротстави ономе што је пре било непобедиво. Неке болести више нису биле смртоносне. Пролазиле су за пар дана од давања ињекција пеницилина.
Историја ретко даје прилику да један тренутак, један увид, испише судбину милиона. А ипак, Флеминг је тај тренутак доживео у тишини своје лабораторије, док свет није ни слутио шта се дешава. Пеницилин је постао симбол моћи људског ума и тихе револуције која мења животе. Човечанство је скоро неприметно, кренуло у нову еру. Један тренутак, један увид, једна супстанца и свет више никада неће бити исти.
Један круг на Петријевој плочици отворио је пут не само пеницилину, већ и читавом сложеном и непрегледном систему будућих медицинских открића. Сваки нов извојеван људски живот, свака побеђена инфекција, сведоче о моћи пажљиве упорности и запажања једног човека да промени свет.

